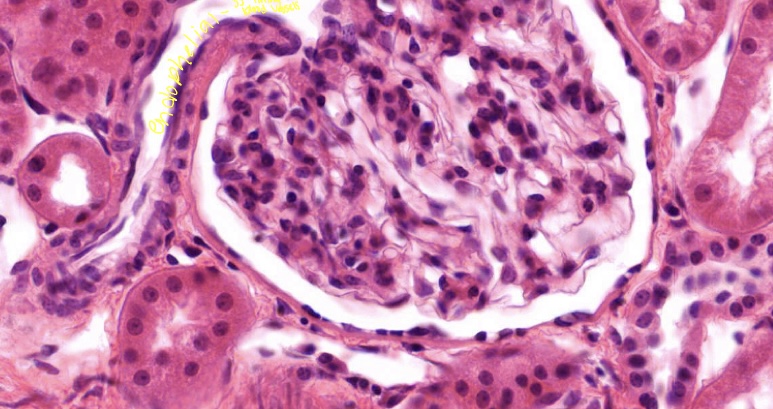
term image

Pre matr anatomy part 1
0.0(0)
Card Sorting
1/117
There's no tags or description
Looks like no tags are added yet.
Last updated 12:10 PM on 7/20/23
Name | Mastery | Learn | Test | Matching | Spaced | Call with Kai |
|---|
No analytics yet
Send a link to your students to track their progress
118 Terms
1
New cards
4 divisions of anatomy
gross, micro/histology, embryology, and neuroanatomy
2
New cards
oldest, structures seen in dissections and imaging
gross
3
New cards
only seen via microscope, study of cells and tissues and organs
microanatomy
4
New cards
development from fertilization until birth
embryology
5
New cards
structures and functions of the cns pns and ans
neuroanatomy
6
New cards
anatomical position
heads, eyes and toes directed forward(anteriorly). upper limbs to the side with palms open and anteriorly. legs closed and feet parallel
7
New cards

\
\
\
\
\
\
\
\
\
\
\
\
\
\
\
1
\
\
\
\
\
\
\
\
\
\
\
\
\
\
\
1
\
Median plane of the body
8
New cards
Median plane divides the body
Vertical plane passing though the midline of the body and bisects it into left and right
9
New cards

2
SAGITTAL plane
10
New cards
Sagittal plane
Passing through the body parallel to the medial plane diving the body into uneven left and right sections
11
New cards

\
Coronal plane
12
New cards
Coronal plane
Vertical plane dividing the body into front and back/ anterior and posterior halves
13
New cards

1
Transverse/ axial plane
14
New cards
Transverse plane
Horizontal plane dividing the body into top and bottom halves
15
New cards

2
Frontal plane
16
New cards

1) longitudinal
2) transverse
3) oblique
2) transverse
3) oblique
17
New cards
Proximal
Closer to the orgin
18
New cards
Distal
Further from the orgin
19
New cards
Medial
Near the midline
20
New cards
Lateral
Further from the midline
21
New cards
Superior
Towards the head
22
New cards
Inferior
Closer to the sole of the floor
23
New cards
Anterior/ ventral
Front of the body
24
New cards
Posterior / dorsal
Back of the body
25
New cards

Green
Extension
26
New cards

Blue
Flexion
27
New cards
Flexion
Bending or decreasing the angle between the bones of the body
28
New cards
Extension
Straightening or increasing the angle between the bones
29
New cards

Blue
Dorsiflexion
30
New cards

Green
Plantarflexion
31
New cards
Dorsiflexion
Flexion at the ankle when walking uphill or lifting the floor of the foot and toes off the ground
32
New cards
Plantar flexion
Bends the foot towards the ground as when standing on your
33
New cards

1
Abduction
34
New cards

2
Adduction
35
New cards

3
Lateral rotation
36
New cards

4
Medial rotation
37
New cards

5
Circumduction
38
New cards

6
Supination
39
New cards

7
Pronation
40
New cards

8
Opposition
41
New cards

9
Reposition
42
New cards

1
Retrusion
43
New cards

2
Protrusion
44
New cards

3
Elevation
45
New cards

4
Depression
46
New cards

9
Eversion
47
New cards

10
Inversion
48
New cards
Abduction
Moving from the median plane
49
New cards
Adduction
Moving towards the median plane
50
New cards
Circumdution
Circular movement with Flexion , abduction, extension
51
New cards
Medial rotation
Internal rotation that brings the anterior surface of a limb closer to the median plane
52
New cards
Lateral rotation
External rotation brings the anterior surface away from the median plane
53
New cards
Pronation
Palm posterior and dorsum anterior
54
New cards
Supination
Palm up ( can hold soup)
55
New cards
Eversion
Move the sole away from the median plane
56
New cards
Inversion
The sole of the foot towards the median plane
57
New cards
Opposition
Pad of the thumb is brought to another finger pad
58
New cards
Reposition
Moving the opposite position back to the anatomical position
59
New cards
Protrusion
Moving the chin lips out tongue forward/anteriorly
60
New cards
Retrusion
Moving the chin, lips, and tongue back/posteriorly
61
New cards
4 main types of medical imaging used by clinicians
Radiographs, CAT/ct scans, MRI and Ultrasound
62
New cards
Oldest imaging techniques using an X-ray source and a film best for bones and picks up densities in tissues
Radiographs
63
New cards

Radiographs
64
New cards
X-ray source and detector rotates around the patient, can be done quickly, gives horizontal planes, view images as though standing at a patients feet and is best for dense tissues
CT
65
New cards

CT
66
New cards
Protons align by a strong magnetic field, safe due to no ionizing radiation, better for soft tissue, provides less info about bones, and people with metallic implants/pacemakers cant use
MRI’s
67
New cards
Uses sound waves reflect tissues safe for preggo and kids real time images of moving structures
Ultrasound
68
New cards

Ultrasounds
69
New cards
4 basic tissues
Epithelia, CT, muscle, and nervous
70
New cards
All tissues of the body are derived from 3 germ layers
Ectoderm, mesoderm, and endoderm
71
New cards
Tumors mostly in ovaries, derived from all 3 germ layers, can grow teeth hair muscle cell and epithelium
Dermoid cyst
72
New cards

Dermoid cyst
73
New cards
Covers body surface, lines body cavities, forms glands, cells are touching, avascular , joined by specialized junctions, surface specializations, and separated from underlying ct by basal lamina
Epithelia
74
New cards
Body surface epithelium (epidermis) is derived from
Ectoderm
75
New cards
Epithelium lining body cavities is derived from
Endoderm
76
New cards
Kidney epithelium is derived from
Mesoderm
77
New cards
Sweat Glands are formed from
Ectoderm
78
New cards
Liver and pancreas glands are derived from
Endoderm
79
New cards
How are epithelia classified
Number of layers and cell shape of the top layer
80
New cards
Simple
Epithelia with one layer of cells
81
New cards
Stratified
More than one layer of cells
82
New cards
Pseudostratified
Seems to be more than one layer
83
New cards
Squamous
Flattened cells
84
New cards
Cuboidal
Square cells
85
New cards
Columnar
Tall cells
86
New cards
Transitional epithelium
Cells in the urinary system where the cell shape adapts in order to stretch to hold urine
87
New cards

Simple squamous
Strat squamous
Strat squamous
88
New cards

Simple cuboidal and strat cuboidal
89
New cards

Simple columnar and Startified columnar
90
New cards

Pseudostratified columnar and transitional
91
New cards

Mesentery simple squamous cells
92
New cards
Simple squamous in bowman capsule kidney
93
New cards

Stratified cubodial in sweat glands
94
New cards

Strat squamous in esophagus. Top cells are flat, living cells not keratinized
95
New cards

Cilia in trachea specializing in moving food
96
New cards

Microvilli in small intestine to help absorb food
97
New cards
Derived from mesoderm, separated from eachother by Extracellular matrix
Connective tissue
98
New cards
Connective tissue is classified as
CT proper dense, CT proper loose, adipose, bone, cartilage, and blood
99
New cards
CT proper with More fibers than cells
Dense
100
New cards
Ct proper with more cells
Loose